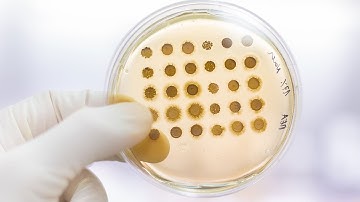
Elementary Business Statistics | Central Limit Theorem for Sample Means

⬇ DOWNLOAD NOW
Kalau muncul iklan pop-up, tutup lalu klik tombol kembali
Download lagu Elementary Business Statistics | Central Limit Theorem: Overview secara gratis hanya untuk keperluan promosi. Dukung artis favorit kamu dengan membeli musik original di iTunes atau platform resmi lainnya.
 Elementary Business Statistics | Using the Central Limit Theorem: Proof by Simulation
Elementary Business Statistics | Using the Central Limit Theorem: Proof by Simulation
 The Central Limit Theorem, Clearly Explained!!!
The Central Limit Theorem, Clearly Explained!!!
 Central limit theorem
Central limit theorem
 Elementary Business Statistics | Central Limit Theorem: Summary
Elementary Business Statistics | Central Limit Theorem: Summary
 Introduction to the Central Limit Theorem
Introduction to the Central Limit Theorem
 02 - What is the Central Limit Theorem in Statistics? - Part 1
02 - What is the Central Limit Theorem in Statistics? - Part 1
Elementary Business Statistics | Central Limit Theorem for Sample Means
Elementary Business Statistics | Central Limit Theorem for Sample Means
 The Central Limit Theorem - understanding what it is and why it works
The Central Limit Theorem - understanding what it is and why it works